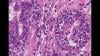

This is a quick walk around of the new Siemens Somatom Go.top cardiovascular edition compact computed tomography (CT) scanner on display at the Society Of Cardiovascular Computed Tomography (SCCT) 2019 meeting in July. It is aimed at cardiology office based imaging and was released this past spring at the American College of Cardiology (ACC) meeting.
The system has removable tablets on each side of the scanner where the tech can adjust the machine, review scout scans and trigger the scanner. The idea is to improve workflow and allow the tech to remain at the bedside longer to be with the patient, rather tucked away in a remote control room using an intercom.
The entire system is built into the gantry seen here, so there is no need for extra equipment in a closet, cabinet or server tower.
It comes in a 128 slice configuration with 4 cm of anatomical coverage per rotation.
It uses the Stellar detector and tin filtration to eliminate low energy photons and help lower dose. It can be programmed to aid workflow by automatically removing bone, create cured planar reconstructions, lung CAD and other post-processing features so more time can be spent on reading scans. The scanner also comes with a HeartFlow FFR-CT starter pack.
Find more information on this system in these related articles:
New Cardiovascular CT Technology Entering the Market
New Technology Highlights on the ACC 2019 Exhibit Floor